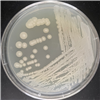

Korean Collection for Type Cultures
KCTC에서는 일반자원 분양과 특허자원 분양 서비스를 제공 합니다.
Distribution
분양
KCTC 7834
| KCTC No. | 7834 |
|---|---|
| (KCTC Other No.) | |
| Resource Type | Yeast |
| Name | Hanseniaspora uvarum |
| Type Strain | No |
| Biosafty Level | 1 |
| LMO | No |
| Synonym | |
| Phylum (ex Phylum) | |
| Genome Information | |
| History | <- S.G. Hong, SG99-31 |
| Source | From rotten part of peach |
| Other Collection No. | |
| Reference | |
| KCTC Media No. |
KCTC media No. 26 YM Agar or YM Broth |
| Oxygen Requirement | Aerobic |
| Temperature | 24 ℃ |
| pH | netural pH 배양 가능 (배지정보 참조) |
| Incubation Time | |
| Images |

|
| Price |
[Delivery form & Price]
- Freeze vial (일반 분양) : ₩50,000 KRW - Actively growing culture (활성배양체 분양) : ₩75,000 KRW * 주문시 현재 금액에서 부가가치세 10%가 추가 됩니다 * 동물세포주 일반 분양은 드라이아이스비용(packing charges 20,000원)이 별도로 추가 됩니다. ※ 동물세포주 방문 수령의 경우 별도로 드라이아이스 혹은 액체질소를 가지고 오셔야 합니다. |
| MTA Restrictions | Only NON-COMMERCIAL USE for reference strains and/or academic researches |
| Overseas Export Approval | 본 자원은 국외반출승인대상이 아닙니다. |
* KCTC에서 분양받은 자원을 이용하여 논문이나 특허에 사용하실 경우, ‘본 연구에 사용된 생물자원은 KCTC로부터 제공받았음’ 문구를 반드시
기재해주시기 바랍니다.
(영문 : The biological resources used in this research were distributed from KCTC.)
 MICROBIOTA
MICROBIOTA







 담당자
담당자 기탁/분양서류
기탁/분양서류 DNA분양서비스
DNA분양서비스 동결건조서비스
동결건조서비스 STR분석서비스
STR분석서비스